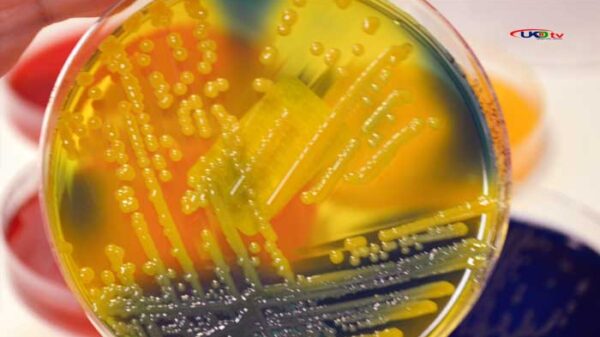

প্রযুক্তি জায়ান্ট গুগল ব্যবহারকারীদের বিনামূল্যে ১৫ জিবি স্টোরেজ দেয়। সেটি শেষ হয়ে গেলে স্টোরেজ কিনতে হয়। তা বেশ খরচসাপেক্ষ। তাই খুব প্রয়োজন না হলে সেটি কেউ কিনতে চান না। নিয়মিত
বিশ্বের শীর্ষ ধনী ইলন মাস্কের টুইটারকে টেক্কা দিতে নতুন মাইক্রোব্লগিং সাইট আনছেন ফেসবুকের মূল প্রতিষ্ঠান মেটার সিইও মার্ক জাকারবার্গ। বৃহস্পতিবার থেকে অ্যাপল অ্যাপস্টোরে পাওয়া যাবে থ্রেডস নামের অ্যাপটি। রয়টার্সের এক
সম্প্রতি ইউক্রেনে ভয়ংকর এক ব্যাকটেরিয়ার সন্ধান পেয়েছেন গবেষকরা। এই মরণব্যাধি ব্যাকটেরিয়ার বিরুদ্ধে অ্যান্টিবায়োটিক তৈরি না হলে এটি খুব দ্রুত পুরো ইউরোপে ছড়িয়ে পড়তে পারে বলে আশঙ্কা করা হচ্ছে, যা কোভিড
বিশ্বসেরা গবেষকদের তালিকায় স্থান পেয়েছেন শাহজালাল বিজ্ঞান ও প্রযুক্তি বিশ্ববিদ্যালয়ের (শাবিপ্রবি) বিভিন্ন বিভাগের ২২৫ জন গবেষক। সম্প্রতি প্রকাশিত অ্যালপার ডগার (এডি) সায়েন্টিফিক ইনডেক্স কর্তৃক প্রকাশিত র্যাংকিংয়ে বিশ্ব সেরাদের মধ্যে এ
বাংলাদেশের তরুণ বিজ্ঞানী ড. সেঁজুতি সাহাকে অভিনন্দন জানিয়েছেন মাইক্রোসফট কর্পোরেশনের সহ-প্রতিষ্ঠাতা বিল গেটস। সম্প্রতি সেঁজুতি সাহা ২০২৩ সালে এশিয়ার শীর্ষ ১০০ বিজ্ঞানীর একজন হিসেবে স্বীকৃত হওয়ায় বুধবার এই শুভেচ্ছা বিল
আওয়ামী লীগের ৭৪তম প্রতিষ্ঠাবার্ষিকীতে শুভেচ্ছা জানিয়েছেন আওয়ামী লীগের সভানেত্রী প্রধানমন্ত্রী শেখ হাসিনার ছেলে ও তথ্য প্রযুক্তি বিষয়ক উপদেষ্টা সজীব ওয়াজেদ জয়। বৃহস্পতিবার (২২ জুন) রাতে নিজের ভেরিফাইড ফেসবুক পেজে একটি
বাংলাদেশের প্রথম সোস্যাল কমার্স প্ল্যাটফর্ম ফ্যানফেয়ার বাংলাদেশ। যেটি ভিডিও শেয়ারিং প্ল্যাটফর্ম ও ই-কমার্স হিসেবে কাজ করছে। প্রতিষ্ঠানটি দেশের স্বনামধন্য বিভিন্ন ব্র্যান্ড ও ইউজারদেরকে প্রাধান্য দিয়ে সফলতার সাথে কাজ করে আসছে।
সিলেট সিটি করপোরেশন (সিসিক) নির্বাচনে ভোটযুদ্ধ বুধবার (২১ জুন)। এরই মধ্যে সোমবার মধ্যরাতে আনুষ্ঠানিক প্রচারণা-প্রচারণা শেষ হয়েছে। প্রার্থী-সমর্থকরা মেলাচ্ছেন ভোটের হিসাব। নেই কান ফাটা মাইকের শব্দ। তবে মেয়র-কাউন্সিলর প্রার্থী-সমর্থকরা এখন
মুরগি আগে, না ডিম আগে? যুগ যুগ ধরে এই তর্ক চলেছে। কিন্তু কোনটি আগে তা নিয়ে সন্দেহ থেকেই গেছে। অনেকের দাবি মুরগি আগে এসেছে। আবার অনেকে বলছেন মুরগি নয়, ডিমই
অনলাইনে জুয়া ও ফেসবুকসহ সামাজিক মিডিয়ায় দেশবিরোধী অপপ্রচারসহ নানাবিধ অপরাধমূলক কার্যক্রম বন্ধে সরকারের পক্ষ থেকে কার্যকর ব্যবস্থা গ্রহণ করা হয়েছে বলে জানিয়েছে স্বরাষ্ট্র মন্ত্রণালয়। বুধবার জাতীয় সংসদ ভবনে অনুষ্ঠিত স্বরাষ্ট্র